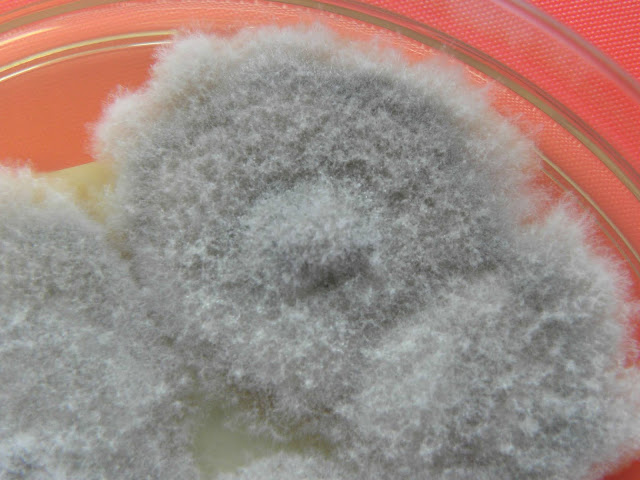

SCEDOSPORIUM
Recentemente, foi possível desdobrar, através de análise molecular, a espécie S. apiospermum em quatro espécies distintas: S. aurantiacum, S. boydii, S. apiospermum e S. dehoogii. A identificação à espécie apenas pela observação macroscópica e microscópica do fungo é impossível, apenas a análise por biologia molecular é exequível.
São responsáveis, sobretudo, por micetomas, infeções do globo ocular, ouvido e sistema nervoso central.
Na fibrose quística ocupa o segundo lugar depois do Aspergillus, entre os fungos associados à colonização crónica das vias aéreas.
Devido ao seu crescimento lento, mesmo relativamente aos outros fungos filamentosos, é difícil o isolamento em cultura devido à competição pelos nutrientes. Este facto, levou ao desenvolvimento de um meio semi-seletivo: o scedo-select III (sce-sel). A aplicação prática deste meio ocorre. em estudos do meio ambiente
As manifestações clínicas vão desde a infeção local, colonização pulmonar até doença invasiva, na qual as taxas de mortalidade podem ser superiores a 80%. Estas taxas levadas são devido ao estado clínico dos pacientes, às dificuldades de diagnóstico, e à resistência antifúngica intrínseca destes fungos.
Estão descritas resistências do Scedosporium a uma vasta gama de antifúngicos, incluindo os polienos (anfotericina B e nistatina) e azóis (fluconazol, itraconazol, e isavuconazol) e uma susceptibilidade reduzida às equinocandinas (caspofungina e anidulafungina)
Para o tratamento de infeções por Scedosporium as diretrizes europeias recomendam o voriconazol como tratamento de primeira linha juntamente com o desbridamento cirúrgico quando possível. Embora tenham sido observados resultados favoráveis na sequência de tais recomendações, o resultado continua pobre, com taxas de mortalidade de >65% e quase 100% quando ocorre a afetação ou disseminação do SNC.
As soluções de identificação MALDI-TOF/MS atualmente disponíveis no mercado são inadequadas para Scedosporium, será necessário o desenvolvimento de uma base de dados mais robusta. A criação e disponibilização destas bases de dados é um passo necessário porque em linha de investigação já se pode afirmar que a espectrometria de massa (MALDI-TOF/MS) se tornou disponível para a primeira linha identificação. É mais económica e a sua a precisão na identificação é comparável à da sequenciação do ADN.
Em 48 horas após a repicagem em meio de Sabouraud pode já ser possível fazer a identificação por análise microscópica da colónia.
Esta estirpe foi responsável por um abcesso da córnea, que não obstante o tratamento antifungico local e sistémico bem com sucessivos transplantes da córnea, evoluiu para endolftalmite com perda da acuidade visual desse olho.. (mais recentemente isolámos outra estirpe em cultura de LCR)
 |
| Colónia com 6 dias de incubação. |
 |
| Colónia com 9 dias de incubação. |
 |
| Reverso de colónia com 9 dias de incubação. |
 |
| Colónia com 14 dias de incubação. |
 |
| Reverso de colónia com 14 dias de incubação. |
 |
| Observam-se numerosos conídios unicelulares clavados a ovóides arredondados com bases truncadas. |
 |
| Os conídeos são produzidas individualmente ou em pequenos grupos, em conidióforos simples ou ramificados conidióforos. |